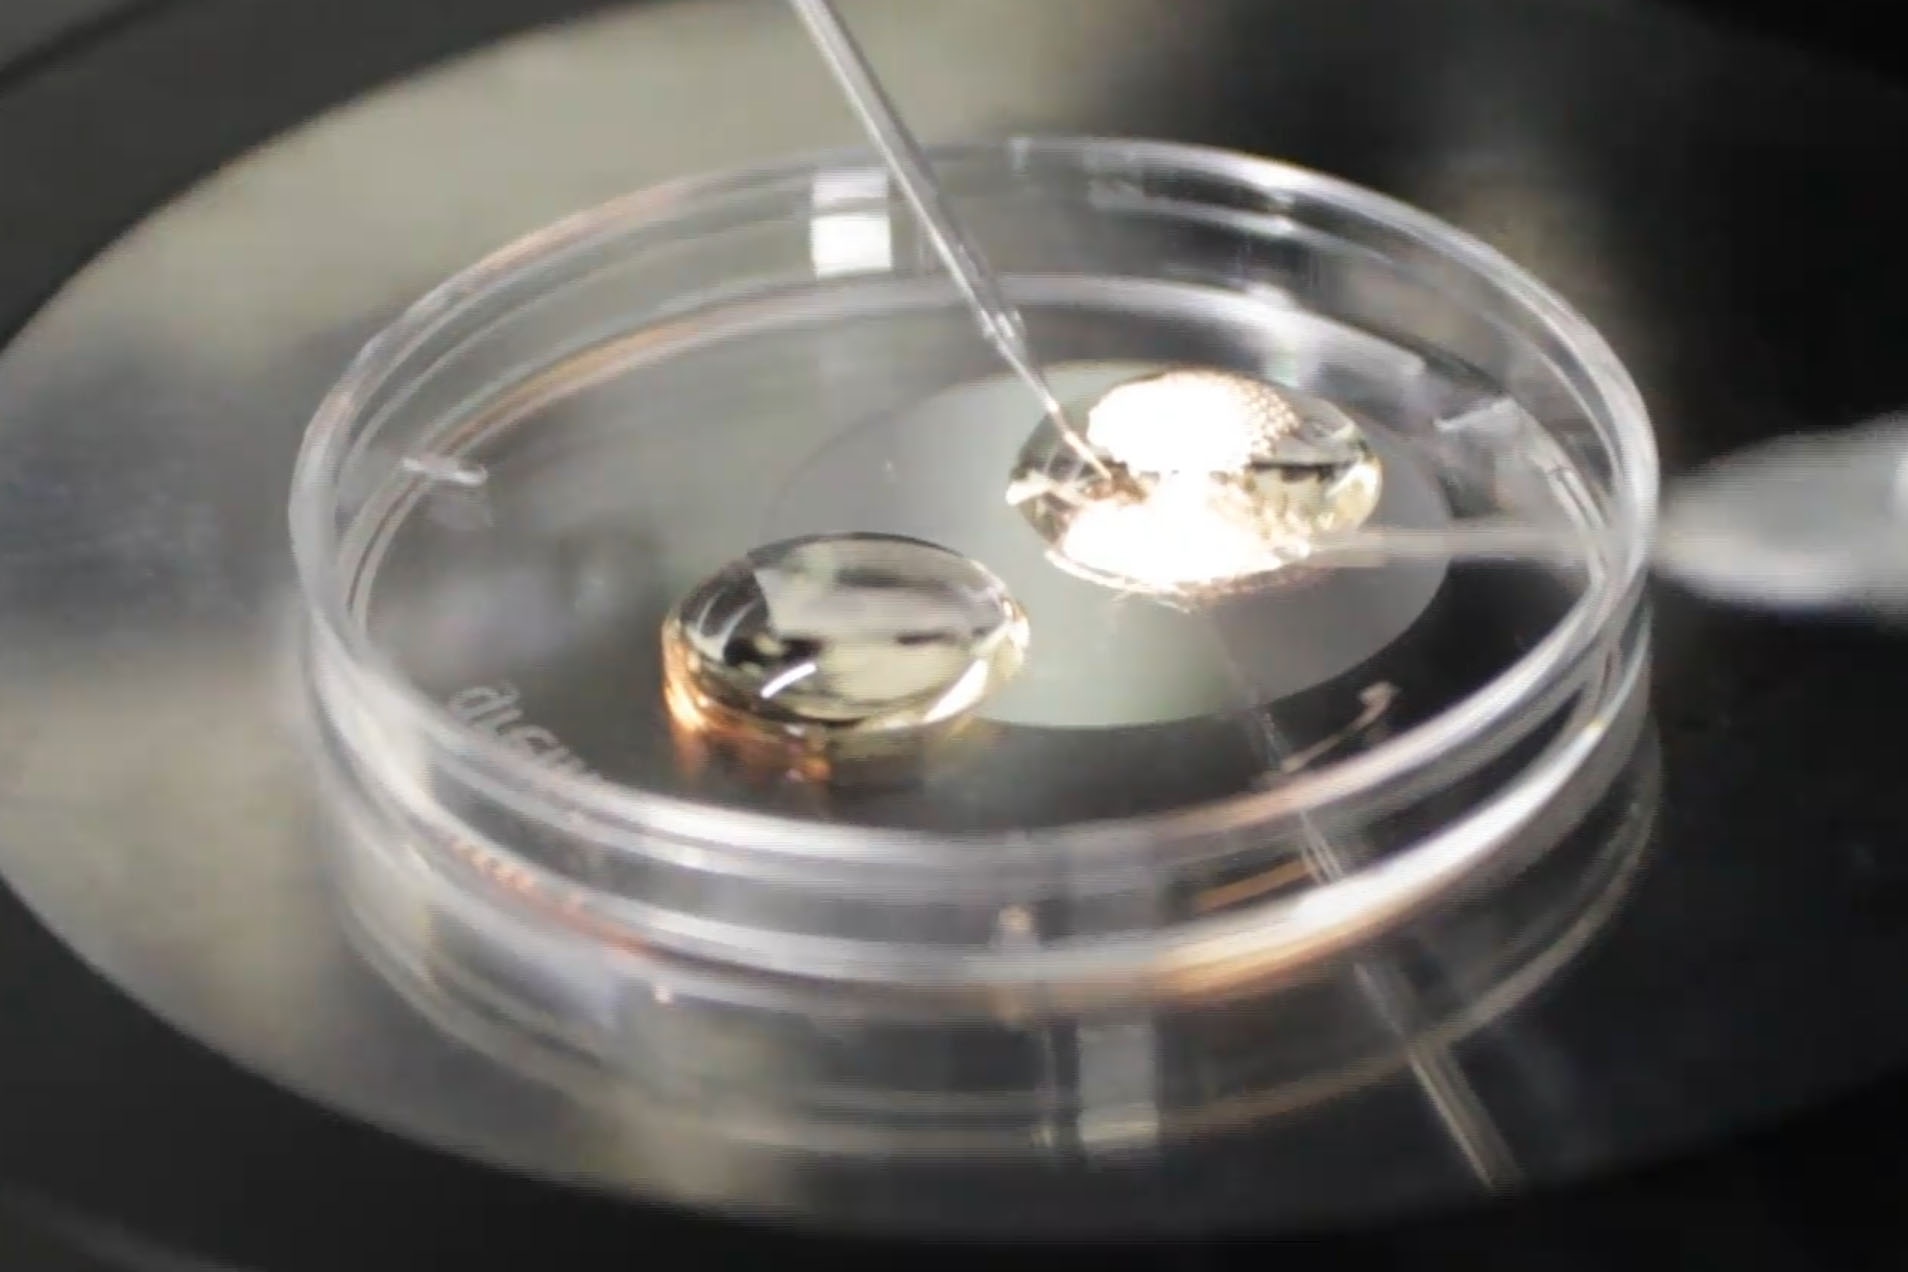
qua trinh thu nghiem vaccine covid-19 anh 2

Thông thường, chuột là loài vật được lựa chọn để xác định liệu phương pháp điều trị có an toàn và hiệu quả hay không. Tuy nhiên, trong cuộc chiến tìm kiếm vắc-xin phòng ngừa Covid-19, các nhà khoa học lại không thể sử dụng những loại chuột thông thường.
Vì sao chuột bình thường là không đủ
Mặc dù cấu trúc gen của chuột cho phép virus lây lan trong cơ thể chúng, các nhà khoa học tin rằng chuột không biểu hiện các triệu chứng mà bệnh tật có thể gây tử vong cho con người.
 |
| Để nghiên cứu vaccine cho Covid-19, các nhà khoa học cần loại chuột đã biến đổi gen để có phản ứng với các triệu chứng bệnh. Ảnh: Jackson Laboratory. |
“Bạn có thể khiến chúng nhiễm virus, nhưng chúng thường không hoặc có rất ít biểu hiện bệnh lâm sàng”, ông Richard Bowen, Giáo sư ngành thú y tại Đại học bang Colorado nhận xét.
Đó là lý do các nhà khoa học thường tìm kiếm giống chuột đã được biến đổi gen bằng cách cấy gen thụ thể ACE2 của con người, khiến virus có tác dụng mạnh hơn trên chuột và do đó nghiên cứu tác dụng của vaccine hiệu quả hơn. Tuy nhiên, khi Covid-19 lan rộng khắp thế giới, các nhà khoa học gần như không thể tìm thấy chuột ACE2 biến đổi gen cần thiết để nghiên cứu.
Theo Bloomberg, chuột biến đổi gen là đối tượng rất cần thiết trong nghiên cứu khoa học, nhưng nguồn cung lại rất ít. Các nhà khoa học sửa đổi gen của chúng để mô phỏng các bệnh lý thường gặp trên người như tiểu đường, ung thư nhằm nghiên cứu kỹ lưỡng hơn.
|
| Để có được giống chuột phù hợp, phòng thí nghiệm phải thay đổi gen của chuột nhằm mô phỏng được dịch bệnh trên cơ thể người. Ảnh: Bloomberg. |
Tại một phòng thí nghiệm ở Tô Châu, Trung Quốc, một đôi chuột biến đổi gen có thể được bán với giá tới 17.000 USD. Tuy nhiên, nhu cầu biến đổi gen để phù hợp với các bệnh dịch luôn biến đổi. Với những dịch bùng phát nhanh như Covid-19, việc lai tạo giống chuột mới khó theo kịp nhu cầu nghiên cứu.
Thế giới gấp rút tạo ra chuột nhiễm Covid-19
Các nhà nghiên cứu cho rằng phải mất vài tuần hoặc vài tháng để phát triển và lai tạo nguồn cung đủ chuột biến đổi gen ACE2. Phòng thí nghiệm Jackson, một tổ chức phi lợi nhuận ở Maine chuyên cung cấp động vật cho các nhà nghiên cứu y tế, bán hơn 11.000 giống chuột.
Nhưng khi virus corona bắt đầu hoành hành trong tháng 1, phòng thí nghiệm đã không có gen cần thiết. Khi các đơn đặt hàng bắt đầu nhiều lên, những nhà nghiên cứu tại phòng thí nghiệm Jackson bắt đầu tìm kiếm nguồn cung chuột nhân bản.
 |
| Nhà khoa học lấy mẫu tinh trùng của chuột từ thiết bị cấp đông. Ảnh: Bloomberg. |
"Các nghiên cứu cũng theo xu hướng, và hiện tại các phòng thí nghiệm chủ yếu tập trung vào các bệnh về ung thư hay tiêu hóa", Kader Thiam, Giám đốc phòng thí nghiệm chuột biến đổi gen GenOway SA tại Pháp nhận xét.
Trong trường hợp của phòng thí nghiệm Jackson, họ đã tìm thấy Stanley Perlman, một chuyên gia về virus chủng corona từng sử dụng chuột biến đổi gen trong cuộc chiến chống lại SARS. Ông Perlman đã phải đóng cửa phòng thí nghiệm của mình hơn 10 năm trước vì không đủ kinh phí duy trì, nhưng vẫn trích xuất các mẫu tinh trùng của chúng phòng trường hợp khẩn cấp.
Tháng trước, ông đã gửi những mẫu này tới phòng thí nghiệm Jackson. Những chuyên gia tại đây hy vọng rằng với những mẫu tinh trùng mà Perlman gửi đến, họ có thể lai tạo thành công các giống chuột nhằm giúp nhiều nhà khoa học trên thế giới tìm cách chế tạo thành công vaccine chống lại virus SARS-CoV2.
Quá trình sinh sản của chuột kéo dài khoảng 3 tuần, và chuột con mất khoảng 6 tuần mới đến tuổi sinh sản. Phòng thí nghiệm Jackson đã nhận đơn đặt hàng nhưng chưa thể đảm bảo thời gian giao hàng cho các đối tác. Một số đơn vị khác như Cyagen Biosciences của Trung Quốc thì hứa hẹn sẽ có chuột vào tháng sau. GenOway cho biết giống chuột phù hợp nhất với virus corona sẽ chỉ có vào năm sau.
Cuộc khủng hoảng về chuột biến đổi gen là một lý do khiến quá trình nghiên cứu vaccine chống dịch bệnh Covid-19 đang gặp khó. Không có chuột để nghiên cứu, các nhà khoa học không thể thử nghiệm đầy đủ các loại thuốc và vaccine tiềm năng.
Tôi biết nhiều người nói về việc thử nghiệm vaccine trực tiếp trên người và bỏ qua giai đoạn thử trên động vật. Đó là việc làm đầy khó khăn và nguy hiểm.
Giáo sư y khoa Flinders University, đại học Flinder, Australia.
Giáo sư Nikolai Petrovsky đến từ Đại học Flinder ở thành phố Adelaide, Australia cho biết thử nghiệm trên động vật là rất cần thiết và với tình cảnh cấp thiết hiện tại, cần tăng tốc quá trình thử nghiệm này.
“Tôi biết một số người đang nói về việc bỏ qua động vật và đi nghiên cứu, thử nghiệm trực tiếp trên con người. Tuy nhiên, điều đó rất khó khăn và sẽ nguy hiểm”, ông Nikolai Petrovsky chia sẻ.
Trong khi đó, một số nhà khoa học lại đang tìm các lựa chọn thay thế khác. Bowen, nhà nghiên cứu tới từ bang Colorado, cho biết ông đã thử nghiệm với chồn, chuột đồng, chuột lang và thỏ, mặc dù chúng đều có nhược điểm so với chuột.
Xavier Saelens, nhà điều tra tại VIB, một viện nghiên cứu khoa học đời sống ở Ghent, Bỉ, đang xem xét khả năng nhân giống chuột tại chỗ, vì việc lấy chúng từ các nguồn thông thường hiện tại là rất khó khăn.


